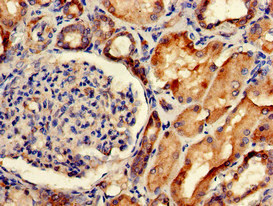

SORCS2 Antibody
-
中文名稱:SORCS2兔多克隆抗體
-
貨號(hào):CSB-PA822282LA01HU
-
規(guī)格:¥440
-
圖片:
-
Immunohistochemistry of paraffin-embedded human brain tissue using CSB-PA822282LA01HU at dilution of 1:100
-
Immunohistochemistry of paraffin-embedded human kidney tissue using CSB-PA822282LA01HU at dilution of 1:100
-
Immunofluorescent analysis of HepG2 cells using CSB-PA822282LA01HU at dilution of 1:100 and Alexa Fluor 488-congugated AffiniPure Goat Anti-Rabbit IgG(H+L)
-
-
其他:
產(chǎn)品詳情
-
產(chǎn)品名稱:Rabbit anti-Homo sapiens (Human) SORCS2 Polyclonal antibody
-
Uniprot No.:
-
基因名:SORCS2
-
別名:SORCS2 antibody; KIAA1329 antibody; VPS10 domain-containing receptor SorCS2 [Cleaved into: SorCS2 122 kDa chain; SorCS2 104 kDa chain; SorCS2 18 kDa chain] antibody
-
宿主:Rabbit
-
反應(yīng)種屬:Human
-
免疫原:Recombinant Human VPS10 domain-containing receptor SorCS2 protein (712-786AA)
-
免疫原種屬:Homo sapiens (Human)
-
標(biāo)記方式:Non-conjugated
本頁面中的產(chǎn)品,SORCS2 Antibody (CSB-PA822282LA01HU),的標(biāo)記方式是Non-conjugated。對(duì)于SORCS2 Antibody,我們還提供其他標(biāo)記。見下表:
-
克隆類型:Polyclonal
-
抗體亞型:IgG
-
純化方式:>95%, Protein G purified
-
濃度:It differs from different batches. Please contact us to confirm it.
-
保存緩沖液:Preservative: 0.03% Proclin 300
Constituents: 50% Glycerol, 0.01M PBS, pH 7.4 -
產(chǎn)品提供形式:Liquid
-
應(yīng)用范圍:ELISA, IHC, IF
-
推薦稀釋比:
Application Recommended Dilution IHC 1:20-1:200 IF 1:50-1:200 -
Protocols:
-
儲(chǔ)存條件:Upon receipt, store at -20°C or -80°C. Avoid repeated freeze.
-
貨期:Basically, we can dispatch the products out in 1-3 working days after receiving your orders. Delivery time maybe differs from different purchasing way or location, please kindly consult your local distributors for specific delivery time.
-
用途:For Research Use Only. Not for use in diagnostic or therapeutic procedures.
相關(guān)產(chǎn)品
靶點(diǎn)詳情
-
功能:The heterodimer formed by NGFR and SORCS2 functions as receptor for the precursor forms of NGF (proNGF) and BDNF (proBDNF). ProNGF and proBDNF binding both promote axon growth cone collapse (in vitro). Plays a role in the regulation of dendritic spine density in hippocampus neurons. Required for normal neurite branching and extension in response to BDNF. Plays a role in BDNF-dependent hippocampal synaptic plasticity. Together with NGFR and NTRK2, is required both for BDNF-mediated synaptic long-term depression and long-term potentiation. ProNGF binding promotes dissociation of TRIO from the heterodimer, which leads to inactivation of RAC1 and/or RAC2 and subsequent reorganization of the actin cytoskeleton. Together with the retromer complex subunit VPS35, required for normal expression of GRIN2A at synapses and dendritic cell membranes. Required for normal expression of the amino acid transporter SLC1A1 at the cell membrane, and thereby contributes to protect cells against oxidative stress.; Does not promote Schwann cell apoptosis in response to proBDNF.; SorCS2 104 kDa chain and SorCS2 18 kDa chain together promote Schwann cell apoptosis in response to proBDNF.
-
基因功能參考文獻(xiàn):
- Here the authors have characterized SorCS1, SorCS2 and SorCS3 using biochemical methods and electron microscopy. They found that their purified extracellular domains co-exist in stable dimeric and monomeric populations. PMID: 28827148
- Sortilin-related receptor CNS expressed 2 (SorCS2) is one of the vacuolar protein sorting 10 family proteins which may be involved in the disease process of amyotrophic lateral sclerosis PMID: 26420026
-
亞細(xì)胞定位:Cell membrane; Single-pass type I membrane protein. Cell projection. Cytoplasmic vesicle membrane; Single-pass type I membrane protein. Early endosome membrane. Recycling endosome membrane. Cell junction, synapse, synaptosome. Perikaryon. Cell projection, dendrite. Cell projection, dendritic spine. Cell junction, synapse, postsynaptic density membrane.
-
蛋白家族:VPS10-related sortilin family, SORCS subfamily
-
組織特異性:Detected on neurons in the caudate region. Detected on neurons in the hippocampus (at protein level). Highly expressed in brain and kidney. Detected at low levels in heart, liver, small intestine, skeletal muscle and thymus.
-
數(shù)據(jù)庫(kù)鏈接:
Most popular with customers
-
-
YWHAB Recombinant Monoclonal Antibody
Applications: ELISA, WB, IHC, IF, FC
Species Reactivity: Human, Mouse, Rat
-
Phospho-YAP1 (S127) Recombinant Monoclonal Antibody
Applications: ELISA, WB, IHC
Species Reactivity: Human
-
-
-
-
-